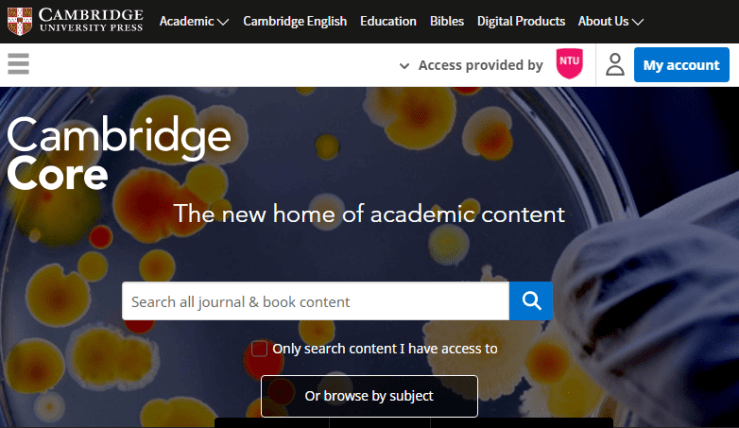
Cambridge University Press

Access to the JISC MediaHub has been withdrawn from Library OneSearch following the conclusion of the service at the start of September. Audio-visual content from the JISC MediaHub is being transferred to the new MediaPlus platform from Alexander Street Press.
Access to MediaPlus has been enabled in Library OneSearch’s Find Databases service. Authentication is direct on-campus and by university username and password from off-campus. The resource is described as follows:
MediaPlus (formerly Jisc MediaHub) will provide the UK higher and further education community with streaming access to more than 100,000 videos, images, and sound recordings, in a range of collections including the archives of ITN, Getty images and Wellcome Library images. MediaPlus also features content from Teachers TV (from Education in Video), World Newsreels Online: 1929–1966, and World History in Video. Content that was previously accessible through the Jisc MediaHub will be loaded onto MediaPlus gradually, with highest-use content, such as ITN News, being released first.
At present, off-campus access requests initiated in the MediaPlus interface will result in an error. ASP’s technical team are working to resolve the issue. Using the secure WAYFLess URL provided in Library OneSearch will ensure that off-campus login requests complete successfully.

You must be logged in to post a comment.